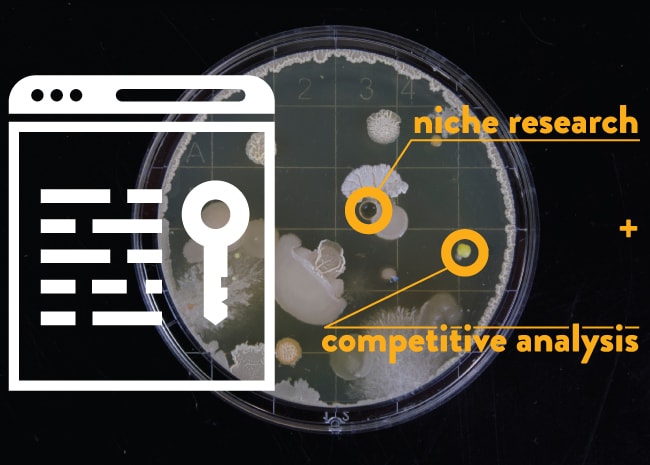
البحث المتخصص والتحليل التنافسي

دليل لإنشاء محتوى من أجل حركة المرور والروابط
نشرت: 2021-10-08المحتوى والروابط هي ركائز تحسين محركات البحث الناجحة.
تستخدم محركات البحث مثل Google مجموعة متنوعة من العوامل لحساب نتائج البحث الخاصة بهم ، لكننا سمعنا من موظفي Google أن المحتوى والروابط هما أهم عاملين للترتيب في البحث:
"يمكنني أن أخبرك ما هم. إنه المحتوى. وهي روابط تشير إلى موقعك ". - أندري ليباتسيف ، كبير إستراتيجيي جودة البحث في Google
في Page One Power ، نحن متخصصون في تسويق المحتوى وبناء الروابط لأن هذه هي الممارسات التي يمكن أن يكون لها أكبر الأثر على عملائنا.

اليوم ، أرغب في إرشادك خلال عمليتين لإنشاء محتوى للبحث - ستتعلم كيفية صياغة محتوى قابل للربط يكسب روابط خلفية طبيعية ذات صلة وكيفية إنشاء محتوى يركز على الكلمات الرئيسية والذي يصنف بسرعة حركة مرور عضوية جديدة ويلتقطها.
دعنا نقفز!
بناء المحتوى للروابط
إذا كنت ترغب في زيادة ظهور موقع الويب الخاص بك وعلامتك التجارية في البحث ، فستحتاج إلى روابط ، وأفضل طريقة لكسب الروابط هي من خلال الترويج لمحتوى يستحق الارتباط.

من خلال سنوات الخبرة في الترويج لصفحات العملاء للحصول على روابط ، حددنا أنواع الصفحات التي تحقق أداءً جيدًا في حملة إنشاء الروابط والسمات التي تجبر مالكي المواقع الآخرين على الارتباط. عادةً ما تكون الصفحات القابلة للربط:
- الانخراط.
- غنيا بالمعلومات.
- أصلي أو فريد.
- قائمة على البيانات ومصادر مناسبة.
- التركيز على الجمهور.
- إلخ.
عنصر رئيسي آخر لصياغة محتوى قابل للربط هو النداء الواسع. يرتبط الأشخاص فقط بالصفحات ذات الصلة بجمهورهم ، لذا فإن الصفحات التي تخدم جماهير أكبر تتمتع بطبيعتها بفرص ارتباط أكبر. ضع في اعتبارك عدد مواقع الويب التي قد ترتبط بصفحة تتعلق بامتلاك الحيوانات الأليفة مقابل صفحة عن رعاية النمس - هناك العديد من الأشخاص الذين قد يرتبطون بصفحة حول امتلاك الحيوانات الأليفة لأنها تتمتع بجاذبية أوسع وأهميتها.
لتوضيح ما يجعل المحتوى قابلاً للربط ، سأقوم بالانسحاب من موقع ويب حقيقي - ShopKeep. على الصفحة الرئيسية لـ ShopKeep ، لاحظت بسرعة قائمة منسدلة تقول "الموارد" والتي تبدو وكأنها مكان واعد للعثور على الأصول القابلة للربط.

يحتوي ShopKeep على دليل لاختيار نقاط البيع الصحيحة ، ولكن يبدو أنه محاط بنموذج ، لذلك لن يكون هذا شيئًا يمكننا الترويج له للروابط. ومع ذلك ، أثناء الاطلاع على المدونة ، لاحظت أن ShopKeep لديه دليل آخر حول التخفيضات الضريبية للشركات الصغيرة:

من خلال القراءة من خلال هذه الصفحة ، أستطيع أن أرى أن لديها القدرة على كسب الروابط - الدليل غني بالمعلومات ، ومنظم جيدًا ، ومصمم لجمهور كبير (أصحاب الشركات الصغيرة والمتوسطة).
عندما أراجع الصفحة في Majestic ، فإنها تُظهر أنه لا يوجد سوى سبعة مجالات مرجعية (مرتبطة):

يشير هذا الرقم المنخفض إلى أن هذه الصفحة قد تكون مقومة بأقل من قيمتها الحقيقية ، ولكن مع الترويج الصحيح ، لديها القدرة على كسب روابط ShopKeep باستمرار.
ولكن ماذا لو لم يكن لدى ShopKeep أي محتوى موجود قابل للربط؟
لصياغة محتوى جديد وجدير بالارتباط ، يجب على ShopKeep اللجوء إلى المنافسين والصناعة للحصول على الإلهام. باستخدام أداة مثل Ahrefs ، يمكنني فرز محتوى منافس للصفحات التي تحتوي على أكثر المجالات إحالة. عند تحليل منافس مثل Square ، يمكنني أن أرى أن لديهم عددًا قليلاً من منشورات المدونة التي تحتوي على أكثر من 40 رابطًا:

تمثل هذه الصفحات موضوعات يحتمل ربطها بـ ShopKeep لمعالجتها بمحتواها.
على سبيل المثال ، يحتوي Square على صفحة حول كيفية تحفيز موظفيك ، والتي تحتوي على 42 مجالًا للإحالة:

دعنا نرى ما إذا كان ShopKeep يغطي هذا الموضوع القابل للربط على مدونتهم:

يبدو أن ShopKeep يفتقد العلامة هنا ، وهناك فرصة لإنشاء محتوى جديد أثبت بالفعل أنه يستحق الارتباط بجمهوره.
لكن هذه مجرد نظرة سريعة على منافس واحد. من خلال التحليل التنافسي ، يمكنك تحديد الاتجاهات والموضوعات التي تعرف أنها ستكسب روابط لأنها تكتسب بالفعل روابط لمنافسيك.

ومع ذلك ، يجب عليك دائمًا البحث في الروابط الخلفية لصفحة منافس أيضًا قبل متابعة صفحتك الخاصة. في Page One Power ، كان لدينا عملاء يجلبون لنا صفحات منافسة تحتوي على قدر كبير من الروابط - يخبروننا أنهم يريدون منا إنشاء صفحة مماثلة لهم - ولكن عندما نراجع هذه الروابط ، نجد أن الغالبية منها غير مرغوب فيها ومنخفضة -الجودة ، أو الروابط التي تم دفع ثمنها بوضوح من خلال عروض الرعاية.
يمكن لصفحات المنافسين التي تحتوي على عدد كبير من الروابط الخلفية أن تشير إلى إمكانية الربط لهذا الموضوع ، ولكن من المهم زيادة تأهيل الموضوع المحتمل من خلال مراجعة تلك الروابط الخلفية.
بناء المحتوى لحركة المرور
الهدف الآخر الذي يجب أن تقدمه صفحاتك هو جلب الزيارات من البحث العضوي. في Page One Power ، نشير إلى هذه الصفحات كمحتوى يركز على الكلمات الرئيسية. تم تصميم عمليتنا لإنشاء صفحات تركز على الكلمات الرئيسية لتحديد الفرص منخفضة المنافسة حيث يمكننا إنشاء صفحات يتم ترتيبها بشكل جيد بسرعة. وكما يوحي الاسم ، يتم ذلك من خلال البحث عن الكلمات الرئيسية.
يتكون البحث الفعال عن الكلمات الرئيسية من عنصرين: البحث المتخصص والتحليل التنافسي. لإجراء هذا البحث ، نود استخدام أداة SEMrush.
في هذا المثال ، سأستخدم موقع TrueCar على الويب للعثور على بعض الفرص المحتملة لهم لإنشاء محتوى يركز على الكلمات الرئيسية.
سأبدأ بتوصيل TrueCar بـ SEMrush:

يوفر SEMrush مجموعة متنوعة من البيانات ، لكننا نستخدمها في البحث التنافسي. للعثور على المنافسين العضويين ، يمكنني التمرير لأسفل ومشاهدة قائمة بهم:


تحدد SEMrush هؤلاء المنافسين بناءً على الكلمات الرئيسية المشتركة ، لذلك قم دائمًا بمراجعة هذه القائمة للتأكد من دقتها. تبدو هذه القائمة جيدة جدًا ، لذا سأبدأ بالبحث في Autotrader.
يساعدني SEMrush في فهم كيفية قيام Autotrader بتوليد حركة مرور عضوية من خلال إظهار النسبة المئوية لحركة المرور العضوية التي تأتي من كلمة رئيسية أو عبارة معينة:

تركز العديد من هذه الكلمات الرئيسية على موضوعات [السيارات المستعملة] أو [وكلاء السيارات] التي لها نوايا تجارية ومن المحتمل أن تكون تنافسية للغاية. ومع ذلك ، فإن إحدى العبارات التي تقفز إليّ هي [اشتر هنا وادفع هنا] حيث يبدو أن Autotrader لديها تصنيف منشور مدونة لهذا المصطلح ، والذي يشير عادةً إلى نية إعلامية:

إن مراجعة منشور مدونة Autotrader يجعلني أؤمن أكثر بأن هذا استعلام معلوماتي:

أيضًا ، المحتوى المقدم هنا بواسطة Autotrader ضعيف إلى حد ما (~ 650 كلمة). أبلغت SEMrush أن هذه الصفحة تحتل المرتبة الثانية لـ [اشتر هنا ادفع هنا] ، لذلك يبدو أن هناك إمكانية هنا لـ TrueCar لإنشاء شيء أفضل يمكن أن يتم تصنيفه. علاوة على ذلك ، يُظهر SEMrush حجم بحث يبلغ 165000 لهذا المصطلح ، لذلك يبدو أن هناك فرصة حقيقية لحركة المرور لـ TrueCar.
ومع ذلك ، للتأكد من أن هذه فرصة قابلة للتطبيق ، سأحتاج إلى التدقيق في بقية نتائج البحث.
التحقق من نتائج [اشتر هنا وادفع هنا] يرسم صورة مختلفة قليلاً:

تهيمن القوائم المحلية لوكلاء السيارات على الجزء العلوي من SERP ، وهناك خمسة وكلاء آخرين مدرجين أدناه قبل أن أرى النتيجة الإعلامية الأولى (Credit Karma):

لهذا السبب يجب عليك دائمًا مراجعة النتائج الفعلية عند إجراء بحث عن الكلمات الرئيسية! نظرًا لأن [اشتر هنا ادفع هنا] يبدو أن له هدفًا تجاريًا ومحليًا إلى حد كبير ، فقد لا تكون هذه فرصة رائعة لـ TrueCar لإنشاء صفحة تركز على الكلمات الرئيسية. ومع ذلك ، أنا لا أستسلم بعد.

أذكر أن صفحة Autotrader كانت بعنوان "ما هو الشراء هنا وادفع هنا؟" - لنرى كيف تبدو نتائج هذا الاستعلام:

تبدو هذه النتائج أكثر إعلامية ، وهناك وظيفة Autotrader مباشرة في الأعلى (منشور Credit Karma في المرتبة أيضًا هنا). على الرغم من وجود بعض العلامات التجارية القوية في الترتيب هنا (Autotrader و Credit Karma و Experian و Wikipedia) ، إلا أن هناك أيضًا تصنيف مواقع ويب أقل شهرة:

بالنظر إلى أن TrueCar هي علامة تجارية معروفة بحد ذاتها ، فقد تكون هذه فرصة واعدة. أعلم بالفعل أن محتوى Autotrader ضعيف إلى حد ما ، لكني بحاجة إلى تحليل بعض النتائج الأخرى لقياس المنافسة بشكل أفضل.
من المحتمل أن يكون لدى Credit Karma و Experian أفضل الصفحات هنا ، ولكن لن يكون من الصعب على TrueCar إنشاء شيء ، إن لم يكن أكثر ، واسع النطاق مثل هذه الصفحات.
تحتوي RoadLoans و LiveAbout على صفحات رفيعة مثل صفحات Autotrader ، وعلى الرغم من أن صفحة AutoSimple مفيدة نسبيًا ، إلا أنها مليئة بالارتباطات التابعة ، ومنسقة بشكل سيئ ، وتحتوي على روابط فيديو معطلة.
أعتقد أن هناك فرصة هنا لـ TrueCar لإنشاء محتوى هو الأفضل في فئته ولديه فرصة قوية للترتيب.
ولكن هل يستحق ذلك؟
المصطلح [what is buy here pay here] له حجم بحث أقل بكثير من [buy here pay here] وفقًا لـ SEMrush:

لكن هذا لا يروي القصة كاملة. عند تقييم حجم البحث ، تحتاج إلى التفكير في أي كلمات رئيسية ذات صلة أو طويلة الذيل مرتبطة بالمصطلح الفردي الذي تستهدفه. على سبيل المثال ، فيما يلي المصطلحات ذات الصلة التي يوفرها SEMrush لـ [ما هو الشراء هنا ادفع هنا]:

هذه الأحجام ليست مثيرة للإعجاب في حد ذاتها ، ولكن إجمالي حجم البحث (ومكاسب عدد الزيارات المحتملة) كبير بشكل إجمالي.
توفر هذه الكلمات الرئيسية ذات الصلة أيضًا مخططًا للصفحة التي يجب على TrueCar إنشاؤها والأقسام والعناوين الفرعية التي يجب أن تتضمنها ("ما هو الشراء هنا ادفع هنا الكثير من السيارات" ، "ما هو تمويل bhph" ، "كيف تشتري هنا تدفع هنا العمل "، وما إلى ذلك).
أخيرًا ، أحتاج إلى مراجعة الروابط الخلفية التي يجب على صفحات التصنيف هذه أن تضمن أنها لن تتطلب 5000 رابط لتكون قادرة على المنافسة. باستخدام Majestic ، يمكنني أن أؤكد بسرعة أن هذه الصفحات مرتبة بروابط قليلة:
- Autotrader - 4 مجالات مرجعية.
- Credit Karma - 7 مجالات مرجعية.
- Experian - 5 مجالات مرجعية.
- RoadLoans - 10 مجالات مرجعية.
- LiveAbout - 16 نطاقًا مرجعيًا.
- تلقائي بسيط - N / A
تجدر الإشارة إلى أن Autotrader و Credit Karma و Experian و LiveAbout جميعها بها أكثر من 20000 رابط خلفي لنطاقاتها. ومع ذلك ، تمتلك TrueCar أيضًا مجالًا قويًا ، مع أكثر من 5000 مجال مرجعي ، ولا ينبغي أن تواجه أي مشكلة في التنافس مع صفحة ذات جودة محسّنة تؤدي أفضل وظيفة للإجابة على نية المستخدم.
وإليكم الأمر - لقد وجدت فرصة لـ TrueCar لإنشاء صفحة تركز على الكلمات الرئيسية ويمكن أن تحصل على ترتيب جيد بسرعة وتحقق حركة مرور عضوية كبيرة.
استنتاج
إذا كان هدفك هو تحسين الأداء العضوي لموقعك ، فستحتاج إلى مزيج صحي من المحتوى يمكنه كسب روابط ومحتوى يمكن أن يتم ترتيبه على أساس الكلمات الرئيسية المستهدفة باستمرار. أنت بحاجة إلى كلا النوعين من المحتوى لترتيب الصفحات الجديدة بشكل موثوق.
نأمل أن يوفر هذا الدليل مخططًا لك لإنشاء أنواع المحتوى التي يمكنها كسب المزيد من الروابط وحركة المرور لموقعك. لا تحتاج إلى كل صفحة على موقعك للحصول على قدر كبير من الروابط أو الترتيب في الصفحة الأولى لمجموعة من المصطلحات ، ولكن هذه الاستراتيجيات ستساعدك في إنشاء بعض الصفحات التي تحقق هذه الأهداف ، ويمكن لهذه الصفحات أن تدعم صفحتك الأخرى المحتوى.
على العكس من ذلك ، إذا كنت بحاجة إلى مساعدة في تسويق المحتوى ، فاتصل بنا وسنعمل معك لإنشاء خطة تساعد موقع الويب الخاص بك على أداء أفضل في البحث.
شكرا للقراءة!
